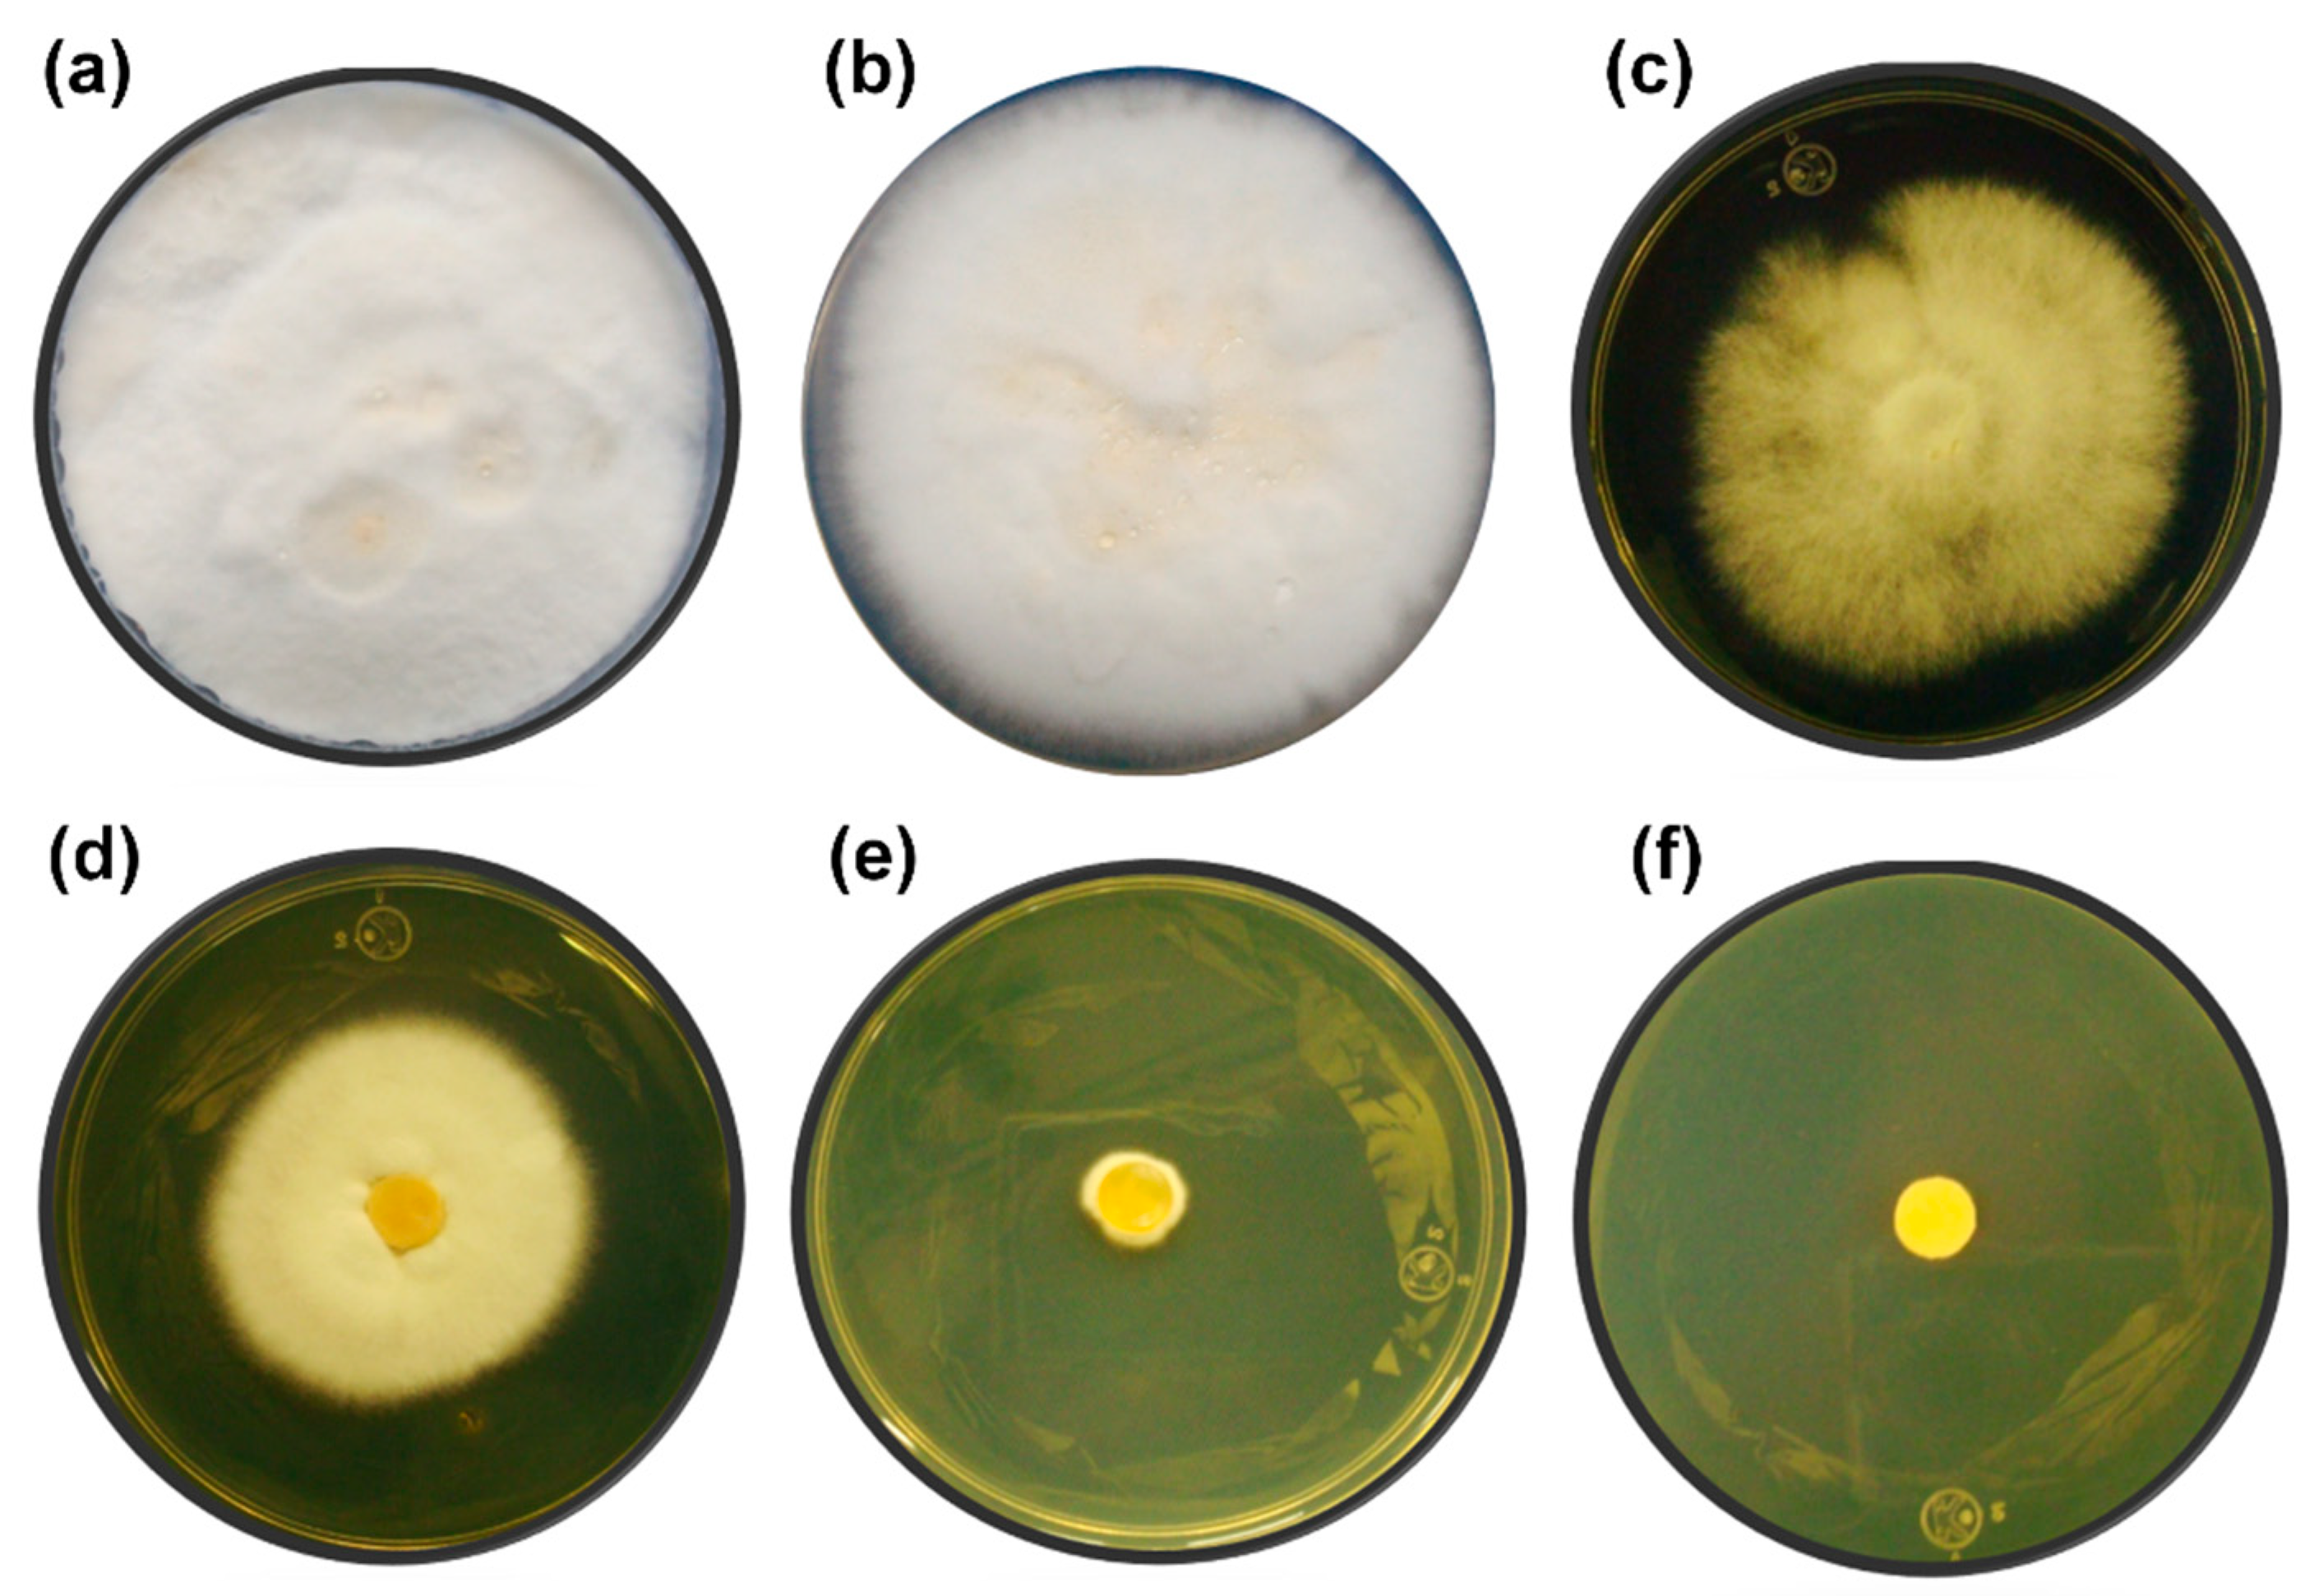
Microorganisms 07 00483 g002 Microorganisms 07 00483 g002

Consolidated Bioprocess for Bioethanol Production from Raw Flour of Brosimum alicastrum Seeds Using the Native Strain of Trametes hirsuta Bm-2
Abstract
1. Introduction
2. Materials and Methods
2.1. Raw Material
2.2. Fungal Strain and Cultivation Conditions
2.3. Enzyme Assay
2.3.1. Analysis of α-amylase Activity
2.3.2. Analysis of Laccase Activity
2.4. Tolerance to Ethanol
2.5. Consolidated Bioprocess Conditions
2.6. Concentration of Ethanol and Glucose
2.7. Physical-Chemical Characterization
3. Results and Discussion
3.1. Enzyme Activity
3.2. Tolerance to Ethanol
3.3. Ethanol Production by CBP with T. hirsuta Bm-2
3.4. Material Flow Balance
3.5. Physical-Chemical Characterization
4. Conclusions
Author Contributions
Funding
Acknowledgments
Conflicts of Interest
References
- Azmah, S.; Abdulla, R.; Hajar, S.; Azhar, M.; Marbawi, H.; Azlan, J.; Ravindra, P. A review on third generation bioethanol feedstock. Renew. Sustain. Energy Rev. 2016, 65, 756–769. [Google Scholar]
- Zabed, H.; Sahu, J.N.; Suely, A.; Boyce, A.N.; Faruq, G. Bioethanol production from renewable sources: Current perspectives and technological progress. Renew. Sustain. Energy Rev. 2017, 71, 475–501. [Google Scholar] [CrossRef]
- Zhao, Y.; Damgaard, A.; Christensen, T.H. Bioethanol from corn stover—A review and technical assessment of alternative biotechnologies. Prog. Energy Combust. Sci. 2018, 67, 275–291. [Google Scholar] [CrossRef]
- Anderson, S.T. The demand for ethanol as a gasoline substitute. J. Environ. Econ. Manag. 2012, 63, 151–168. [Google Scholar] [CrossRef]
- Balat, M.; Balat, H.; Öz, C. Progress in bioethanol processing. Prog. Energy Combust. Sci. 2008, 34, 551–573. [Google Scholar] [CrossRef]
- Naresh, M.; Rajarathinam, K.; Senniyappan, R.; Moorthy, T.; Kumar, R. Choice of Pretreatment Technology for Sustainable Production of Bioethanol from Lignocellulosic Biomass: Bottle Necks and Recommendations. Waste Biomass Valoriz. 2019, 10, 1693–1709. [Google Scholar] [CrossRef]
- Manochio, C.; Andrade, B.R.; Rodriguez, R.P.; Moraes, B.S. Ethanol from biomass: A comparative overview. Renew. Sustain. Energy Rev. 2017, 80, 743–755. [Google Scholar] [CrossRef]
- Mihajlovski, K.; Radovanović, Ž.; Carević, M.; Dimitrijević-Branković, S. Valorization of damaged rice grains: Optimization of bioethanol production by waste brewer’s yeast using an amylolytic potential from the Paenibacillus chitinolyticus CKS1. Fuel 2018, 224, 591–599. [Google Scholar] [CrossRef]
- Sun, J.; Wang, J.; Tian, K.; Dong, Z.; Liu, X.; Permaul, K.; Singh, S.; Prior, B.A.; Wang, Z. A novel strategy for production of ethanol and recovery of xylose from simulated corncob hydrolysate. Biotechnol. Lett. 2018, 40, 781–788. [Google Scholar] [CrossRef]
- Xu, Q.-S.; Yan, Y.-S.; Feng, J.-X. Efficient hydrolysis of raw starch and ethanol fermentation: A novel raw starch-digesting glucoamylase from Penicillium oxalicum. Biotechnol. Biofuels 2016, 9, 216. [Google Scholar] [CrossRef]
- Szambelan, K.; Nowak, J.; Szwengiel, A.; Jeleń, H.; Łukaszewski, G. Separate hydrolysis and fermentation and simultaneous saccharification and fermentation methods in bioethanol production and formation of volatile by-products from selected corn cultivars. Ind. Crops Prod. 2018, 118, 355–361. [Google Scholar] [CrossRef]
- Wilkinson, S.; Smart, K.A.; James, S.; Cook, D.J. Maximising high solid loading enzymatic saccharification yield from acid-catalysed hydrothermally-pretreated brewers spent grain. Biofuel Res. J. 2016, 3, 417–429. [Google Scholar] [CrossRef]
- Jadidzadeh, A.; Serletis, A. The global crude oil market and biofuel agricultural commodity prices. J. Econ. Asymmetries 2018, 18, e00094. [Google Scholar] [CrossRef]
- Tanimura, A.; Kikukawa, M.; Yamaguchi, S.; Kishino, S.; Ogawa, J.; Shima, J. Direct ethanol production from starch using a natural isolate, Scheffersomyces shehatae: Toward consolidated bioprocessing. Sci. Rep. 2015, 5, 9593. [Google Scholar] [CrossRef] [PubMed]
- Raftery, J.P.; Karim, M.N. Biomass and Bioenergy Economic viability of consolidated bioprocessing utilizing multiple biomass substrates for commercial-scale cellulosic bioethanol production. Biomass Bioenergy 2017, 103, 35–46. [Google Scholar] [CrossRef]
- Singh, N.; Mathur, A.S.; Gupta, R.P.; Barrow, C.J.; Tuli, D.; Puri, M. Enhanced cellulosic ethanol production via consolidated bioprocessing by Clostridium thermocellum ATCC 31924. Bioresour. Technol. 2018, 250, 860–867. [Google Scholar] [CrossRef]
- Den Haan, R.; van Rensburg, E.; Rose, S.H.; Görgens, J.F.; van Zyl, W.H. Progress and challenges in the engineering of non-cellulolytic microorganisms for consolidated bioprocessing. Curr. Opin. Biotechnol. 2015, 33, 32–38. [Google Scholar] [CrossRef]
- Amore, A.; Faraco, V. Potential of fungi as category I Consolidated BioProcessing organisms for cellulosic ethanol production. Renew. Sustain. Energy Rev. 2012, 16, 3286–3301. [Google Scholar] [CrossRef]
- Kamei, I.; Hirota, Y.; Mori, T.; Hirai, H.; Meguro, S.; Kondo, R. Direct ethanol production from cellulosic materials by the hypersaline-tolerant white-rot fungus Phlebia sp. MG-60. Bioresour. Technol. 2012, 112, 137–142. [Google Scholar] [CrossRef]
- Gilmore, S.P.; O’Malley, M.A. Microbial communities for bioprocessing: Lessons learned from nature. Curr. Opin. Chem. Eng. 2016, 14, 103–109. [Google Scholar]
- Okamoto, K.; Nitta, Y.; Maekawa, N.; Yanase, H. Enzyme and Microbial Technology Direct ethanol production from starch, wheat bran and rice straw by the white rot fungus Trametes hirsuta. Enzym. Microb. Technol. 2011, 48, 273–277. [Google Scholar] [CrossRef] [PubMed]
- Okamura, T.; Ogata, T.; MINAMOTO, N.; Takeno, T.; Noda, H.; Fukuda, S.; Ohsugi, M. Characteristics of wine produced by mushroom fermentation. Biosci. Biotechnol. Biochem. 2001, 65, 1596–1600. [Google Scholar] [CrossRef] [PubMed]
- Okamoto, K.; Imashiro, K.; Akizawa, Y.; Onimura, A.; Yoneda, M.; Nitta, Y.; Maekawa, N.; Yanase, H. Production of ethanol by the white-rot basidiomycetes Peniophora cinerea and Trametes suaveolens. Biotechnol. Lett. 2010, 32, 909–913. [Google Scholar] [CrossRef] [PubMed]
- Kudahettige, R.L.; Holmgren, M.; Imerzeel, P.; Sellstedt, A. Characterization of Bioethanol Production from Hexoses and Xylose by the White Rot Fungus Trametes versicolor. BioEnergy Res. 2012, 5, 277–285. [Google Scholar] [CrossRef][Green Version]
- Pérez-Pacheco, E.; Moo-Huchin, V.M.; Estrada-León, R.J.; Ortiz-Fernández, A.; May-Hernández, L.H.; Ríos-Soberanis, C.R.; Betancur-Ancona, D. Isolation and characterization of starch obtained from Brosimum alicastrum Swarts Seeds. Carbohydr. Polym. 2014, 101, 920–927. [Google Scholar] [CrossRef] [PubMed]
- González-Hernández, O.; Yoisura-Vergara, S.; Saavedra-Larqué, A. Primeras etapas de crecimiento de Brosimum alicastrum Sw. en Yucatán. Rev. Mex. Cienc. For. 2014, 6, 28–48. [Google Scholar]
- Hernández-González, O.; Vergara-Yoisura, S.; Larqué, S.A. Studies on the productivity of Brosimum alicastrum a tropical tree used for animal feed in the Yucatan Peninsula. Bothalia J. Bothanical Life Sci. Res. 2014, 44, 70–81. [Google Scholar]
- Olguin-Maciel, E.; Larqué-Saavedra, A.; Pérez-Brito, D.; Barahona-Pérez, L.F.; Alzate-Gaviria, L.; Toledano-Thompson, T.; Lappe-Oliveras, P.E.; Huchin-Poot, E.G.; Tapia-Tussell, R. Brosimum alicastrum as a novel starch source for bioethanol production. Energies 2017, 10, 1574. [Google Scholar] [CrossRef]
- Tapia-Tussell, R.; Pérez-Brito, D.; Rojas-Herrera, R.; Cortes-Velazquez, A.; Rivera-Muñoz, G.; Solis-Pereira, S. New laccase—Producing fungi isolates with biotechnological potential in dye decolorization. Afr. J. Biotechnol. 2011, 10, 10134–10142. [Google Scholar]
- Favaro, L.; Viktor, M.J.; Rose, S.H.; Viljoen-bloom, M.; van Zyl, W.H.; Basaglia, M.; Cagnin, L.; Casella, S. Consolidated Bioprocessing of Starchy Substrates Into Ethanol by Industrial Saccharomyces Cerevisiae Strains Secreting Fungal Amylases. Biotechnol. Bioeng. 2015, 112, 1751–1760. [Google Scholar] [CrossRef]
- Ahmed, S.A.; Mostafa, F.A.; Ouis, M.A. Enhancement stability and catalytic activity of immobilized α-amylase using bioactive phospho-silicate glass as a novel inorganic support. Int. J. Biol. Macromol. 2018, 112, 371–382. [Google Scholar] [CrossRef] [PubMed]
- Miller, G.L. Use of dinitrosalicylic acid reagent for determination of reducing sugar. Anal. Chem. 1959, 31, 426–428. [Google Scholar] [CrossRef]
- Johannes, C.; Majcherczyk, A. Natural mediators in the oxidation of polycyclic aromatic hydrocarbons by laccase mediator systems. Appl. Environ. Microbiol. 2000, 66, 524–528. [Google Scholar] [CrossRef] [PubMed]
- Lachance, M.-A. Yeast communities in a natural tequila fermentation. Antonie Van Leeuwenhoek 1995, 68, 151–160. [Google Scholar] [CrossRef]
- Bradford, M.M. A rapid and sensitive method for the quantitation of microgram quantities of protein utilizing the principle of protein-dye binding. Anal. Biochem. 1976, 72, 248–254. [Google Scholar] [CrossRef]
- Holm, J.; Björck, I.; Drews, A.; Asp, N. A rapid method for the analysis of starch. Starch-Stärke 1986, 38, 224–226. [Google Scholar] [CrossRef]
- Ruiz, H.A.; Silva, D.P.; Ruzene, D.S.; Lima, L.F.; Vicente, A.A.; Teixeira, J.A. Bioethanol production from hydrothermal pretreated wheat straw by a flocculating Saccharomyces cerevisiae strain—Effect of process conditions. Fuel 2012, 95, 528–536. [Google Scholar] [CrossRef]
- Shanavas, S.; Padmaja, G.; Moorthy, S.N.; Sajeev, M.S.; Sheriff, J.T. Process optimization for bioethanol production from cassava starch using novel eco-friendly enzymes. Biomass Bioenergy 2011, 35, 901–909. [Google Scholar] [CrossRef]
- Kamei, I.; Hirota, Y.; Meguro, S. Direct Fungal Production of Ethanol from High-Solids Pulps by the Ethanol-fermenting White-rot Fungus Phlebia sp. MG-60. BioResources 2014, 9, 5114–5124. [Google Scholar] [CrossRef]
- Alves, E.; Lucas, G.C.; Pozza, E.A.; de Carvalho Alves, M. Scanning electron microscopy for fungal sample examination. In Laboratory Protocols in Fungal Biology; Springer: Berlin/Heidelberg, Germany, 2013; pp. 133–150. [Google Scholar]
- Tapia-Tussell, R.; Pérez-Brito, D.; Torres-Calzada, C.; Cortés-Velázquez, A.; Alzate-Gaviria, L.; Chablé-Villacís, R.; Solís-Pereira, S. Laccase gene expression and vinasse biodegradation by Trametes hirsuta strain Bm-2. Molecules 2015, 20, 15147–15157. [Google Scholar] [CrossRef]
- Fillat, Ú.; Martín-Sampedro, R.; Ibarra, D.; Macaya, D.; Martín, J.A.; Eugenio, M.E. Potential of the new endophytic fungus Hormonema sp. CECT-13092 for improving processes in lignocellulosic biorefineries: Biofuel production and cellulosic pulp manufacture. J. Chem. Technol. Biotechnol. 2017, 92, 997–1005. [Google Scholar] [CrossRef]
- De Souza, P.M. Application of microbial α-amylase in industry—A review. Braz. J. Microbiol. 2010, 41, 850–861. [Google Scholar] [CrossRef] [PubMed]
- Blanco, A.S.; Durive, O.P.; Pérez, S.B.; Montes, Z.D.; Guerra, N.P. Simultaneous production of amylases and proteases by Bacillus subtilis in brewery wastes. Braz. J. Microbiol. 2016, 47, 665–674. [Google Scholar] [CrossRef] [PubMed]
- Aruna, A.; Nagavalli, M.; Girijashankar, V.; Ponamgi, S.P.D.; Swathisree, V.; Venkateswar Rao, L. Direct bioethanol production by amylolytic yeast C andida albicans. Lett. Appl. Microbiol. 2015, 60, 229–236. [Google Scholar] [CrossRef] [PubMed]
- Castoldi, R.; Bracht, A.; Rodriguez, G.; Morais, D.; Luciano, M.; Carvalho, R.; Correa, G.; Aparecida, R.; de Fátima, R.; Muniz, P.; et al. Biological pretreatment of Eucalyptus grandis sawdust with white-rot fungi: Study of degradation patterns and saccharification kinetics. Chem. Eng. J. 2014, 258, 240–246. [Google Scholar] [CrossRef]
- Pervez, S.; Aman, A.; Iqbal, S.; Siddiqui, N.N.; Ali, S.; Qader, U. Saccharification and liquefaction of cassava starch: An alternative source for the production of bioethanol using amylolytic enzymes by double fermentation process. BMC Biotechnol. 2014, 14, 49. [Google Scholar] [CrossRef]
- Vasina, D.V.; Mustafaev, O.N.; Moiseenko, K.V.; Sadovskaya, N.S.; Glazunova, O.A.; Tyurin, А.А.; Fedorova, T.V.; Pavlov, A.R.; Tyazhelova, T.V.; Goldenkova-Pavlova, I.V.; et al. The Trametes hirsuta 072 laccase multigene family: Genes identification and transcriptional analysis under copper ions induction. Biochimie 2015, 116, 154–164. [Google Scholar] [CrossRef]
- Han, J.R.; An, C.H.; Yuan, J.M. Solid-state fermentation of cornmeal with the basidiomycete Ganoderma lucidum for degrading starch and upgrading nutritional value. J. Appl. Microbiol. 2005, 99, 910–915. [Google Scholar] [CrossRef]
- Zapata-Castillo, P.; Villalonga-Santana, M.D.L.; Tamayo-cortés, J.; Rivera-muñoz, G.; Solís-pereira, S. Purification and characterization of laccase from Trametes hirsuta Bm-2 and its contribution to dye and effluent decolorization. Afr. J. Biotechnol. 2012, 11, 3603–3611. [Google Scholar] [CrossRef]
- Wang, J.; Suzuki, T.; Dohra, H.; Takigami, S.; Kako, H.; Soga, A.; Kamei, I.; Mori, T.; Kawagishi, H.; Hirai, H. Analysis of ethanol fermentation mechanism of ethanol producing white-rot fungus Phlebia sp. MG-60 by RNA-seq. BMC Genom. 2016, 17, 616. [Google Scholar] [CrossRef]
- Xu, Y.; Li, J.; Zhang, M.; Wang, D. Modified simultaneous saccharification and fermentation to enhance bioethanol titers and yields. Fuel 2018, 215, 647–654. [Google Scholar] [CrossRef]
- Paschos, T.; Xiros, C.; Christakopoulos, P. Ethanol effect on metabolic activity of the ethalogenic fungus Fusarium oxysporum. BMC Biotechnol. 2015, 15, 15. [Google Scholar] [CrossRef] [PubMed]
- Mukherjee, V.; Radecka, D.; Aerts, G.; Verstrepen, K.J.; Lievens, B.; Thevelein, J.M. Phenotypic landscape of non-conventional yeast species for different stress tolerance traits desirable in bioethanol fermentation. Biotechnol. Biofuels 2017, 10, 216. [Google Scholar] [CrossRef] [PubMed]
- Radecka, D.; Mukherjee, V.; Mateo, R.Q.; Stojiljkovic, M.; Foulquié-Moreno, M.R.; Thevelein, J.M. Looking beyond Saccharomyces: The potential of non-conventional yeast species for desirable traits in bioethanol fermentation. FEMS Yeast Res. 2015, 15. [Google Scholar] [CrossRef] [PubMed]
- Zapata-Castillo, P.; Villalonga-Santana, L.; Islas-Flores, I.; Rivera-Muñoz, G.; Ancona-Escalante, W.; Solís-Pereira, S. Synergistic action of laccases from Trametes hirsuta Bm2 improves decolourization of indigo carmine. Lett. Appl. Microbiol. 2015, 61, 252–258. [Google Scholar] [CrossRef] [PubMed]
- Avanthi, A.; Mohan, S.V. Single Pot Bioprocessing For Ethanol Production from Biogenic Municipal Solid Waste. Bioresour. Technol. 2019, 283, 159–167. [Google Scholar]
- Viktor, M.J.; Rose, S.H.; van Zyl, W.H.; Viljoen-bloom, M. Raw starch conversion by Saccharomyces cerevisiae expressing Aspergillus tubingensis amylases. Biotechnol. Biofuels 2013, 6, 167. [Google Scholar] [CrossRef]
- Sakwa, L.; Cripwell, R.A.; Rose, S.H. Consolidated bioprocessing of raw starch with Saccharomyces cerevisiae strains expressing fungal alpha-amylase and glucoamylase combinations. FEMS Yeast Res. 2018, 18, foy085. [Google Scholar] [CrossRef]
- Díaz, A.; Bomben, R.; Dini, C.; Viña, S.Z.; García, M.A.; Ponzi, M.; Comelli, N. Jerusalem artichoke tuber flour as a wheat flour substitute for biscuit elaboration. LWT 2019, 108, 361–369. [Google Scholar] [CrossRef]
- Escobar, B.; Pérez-Salcedo, K.Y.; Alonso-Lemus, I.L.; Pacheco, D.; Barbosa, R. N-doped porous carbon from Sargassum spp. as metal-free electrocatalysts for oxygen reduction reaction in alkaline media. Int. J. Hydrog. Energy 2017, 42, 30274–30283. [Google Scholar] [CrossRef]
- Long, G.; Ji, Y.; Pan, H.; Sun, Z.; Li, Y.; Qin, G. Characterization of thermal denaturation structure and morphology of soy glycinin by FTIR and SEM. Int. J. Food Prop. 2015, 18, 763–774. [Google Scholar] [CrossRef]
- Pelissari, F.M.; Andrade-Mahecha, M.M.; do Amaral Sobral, P.J.; Menegalli, F.C. Comparative study on the properties of flour and starch films of plantain bananas (Musa paradisiaca). Food Hydrocoll. 2013, 30, 681–690. [Google Scholar] [CrossRef]
- Silva, T.A.L.; Zamora, H.D.Z.; Varão, L.H.R.; Prado, N.S.; Baffi, M.A.; Pasquini, D. Effect of steam explosion pretreatment catalysed by organic acid and alkali on chemical and structural properties and enzymatic hydrolysis of sugarcane bagasse. Waste Biomass Valoriz. 2018, 9, 2191–2201. [Google Scholar] [CrossRef]
- Gupta, B.S.; Jelle, B.P.; Gao, T. Application of ATR-FTIR spectroscopy to compare the cell materials of wood decay fungi with wood mould fungi. Int. J. Spectrosc. 2015, 2015, 521938. [Google Scholar] [CrossRef]

| Substrate | Microorganism | Ethanol [g/L] | Referencia |
|---|---|---|---|
| Corn starch | Saccharomyces cerevisiae Mnua1 | 9.03 after 240 d | [58] |
| Raw starch and glucose | S. cerevisiae Y294[AteA-GlaA] | 45.77 after 144 h | [59] |
| Raw starch and glucosa | S. cerevisiae Y294[GlaA-AteA] | 45.85 after 144 h | [59] |
| Soluble starch | Scheffersomyces shehatae JCM 18690 | 9.2 after 240 h | [14] |
| Starch | Trametes hirsuta | 9.1 after 96 h | [21] |
| Raw Ramon Flour | T. hirsuta Bm-2 | 13 after 288 h | This work |
| Component | RF (Control) g | RF (12 Days after Inoculated) g | % Material Consumed |
|---|---|---|---|
| Starch | 8.11 ± 0.67 | 2.60 ± 0.35 | 67 |
| Protein | 1.63 ± 0.44 | 0.66 ± 0.50 | 59 |
| Others | 3.56 ± 0.50 | 0.88 ± 0.34 | 75 |
| Sample | N (wt %) | C (wt %) | H (wt %) |
|---|---|---|---|
| Initial RF | 2.04 ± 0.10 | 41.22 ± 0.80 | 6.41 ± 0.01 |
| Residual RF | 2.79 ± 0.18 | 41.87 ± 0.16 | 6.10 ± 0.04 |
© 2019 by the authors. Licensee MDPI, Basel, Switzerland. This article is an open access article distributed under the terms and conditions of the Creative Commons Attribution (CC BY) license (http://creativecommons.org/licenses/by/4.0/).
Share and Cite
Olguin-Maciel, E.; Larqué-Saavedra, A.; Lappe-Oliveras, P.E.; Barahona-Pérez, L.F.; Alzate-Gaviria, L.; Chablé-Villacis, R.; Domínguez-Maldonado, J.; Pacheco-Catalán, D.; Ruíz, H.A.; Tapia-Tussell, R. Consolidated Bioprocess for Bioethanol Production from Raw Flour of Brosimum alicastrum Seeds Using the Native Strain of Trametes hirsuta Bm-2. Microorganisms 2019, 7, 483. https://doi.org/10.3390/microorganisms7110483
Olguin-Maciel E, Larqué-Saavedra A, Lappe-Oliveras PE, Barahona-Pérez LF, Alzate-Gaviria L, Chablé-Villacis R, Domínguez-Maldonado J, Pacheco-Catalán D, Ruíz HA, Tapia-Tussell R. Consolidated Bioprocess for Bioethanol Production from Raw Flour of Brosimum alicastrum Seeds Using the Native Strain of Trametes hirsuta Bm-2. Microorganisms. 2019; 7(11):483. https://doi.org/10.3390/microorganisms7110483
Chicago/Turabian StyleOlguin-Maciel, Edgar, Alfonso Larqué-Saavedra, Patricia E. Lappe-Oliveras, Luis F. Barahona-Pérez, Liliana Alzate-Gaviria, Rubí Chablé-Villacis, Jorge Domínguez-Maldonado, Daniella Pacheco-Catalán, Hector A. Ruíz, and Raúl Tapia-Tussell. 2019. "Consolidated Bioprocess for Bioethanol Production from Raw Flour of Brosimum alicastrum Seeds Using the Native Strain of Trametes hirsuta Bm-2" Microorganisms 7, no. 11: 483. https://doi.org/10.3390/microorganisms7110483
APA StyleOlguin-Maciel, E., Larqué-Saavedra, A., Lappe-Oliveras, P. E., Barahona-Pérez, L. F., Alzate-Gaviria, L., Chablé-Villacis, R., Domínguez-Maldonado, J., Pacheco-Catalán, D., Ruíz, H. A., & Tapia-Tussell, R. (2019). Consolidated Bioprocess for Bioethanol Production from Raw Flour of Brosimum alicastrum Seeds Using the Native Strain of Trametes hirsuta Bm-2. Microorganisms, 7(11), 483. https://doi.org/10.3390/microorganisms7110483

